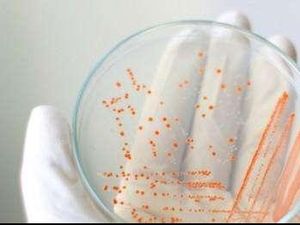
6 Benda Tak Terduga yang Bisa Jadi Sarang Kuman dan Bakteri

detikHealthKamis, 13 Sep 2018 12:03 WIB
detikHealthKamis, 13 Sep 2018 12:03 WIB
Hati-Hati! Mencuci Tangan Terlalu Sering Berbahaya untuk Kesehatan
Mencuci tangan memang baik untuk menghilangkan bakteri. Tapi yang perlu diketahui adalah terlalu sering mencuci tangan juga berisiko mengancam kesehatan kita.